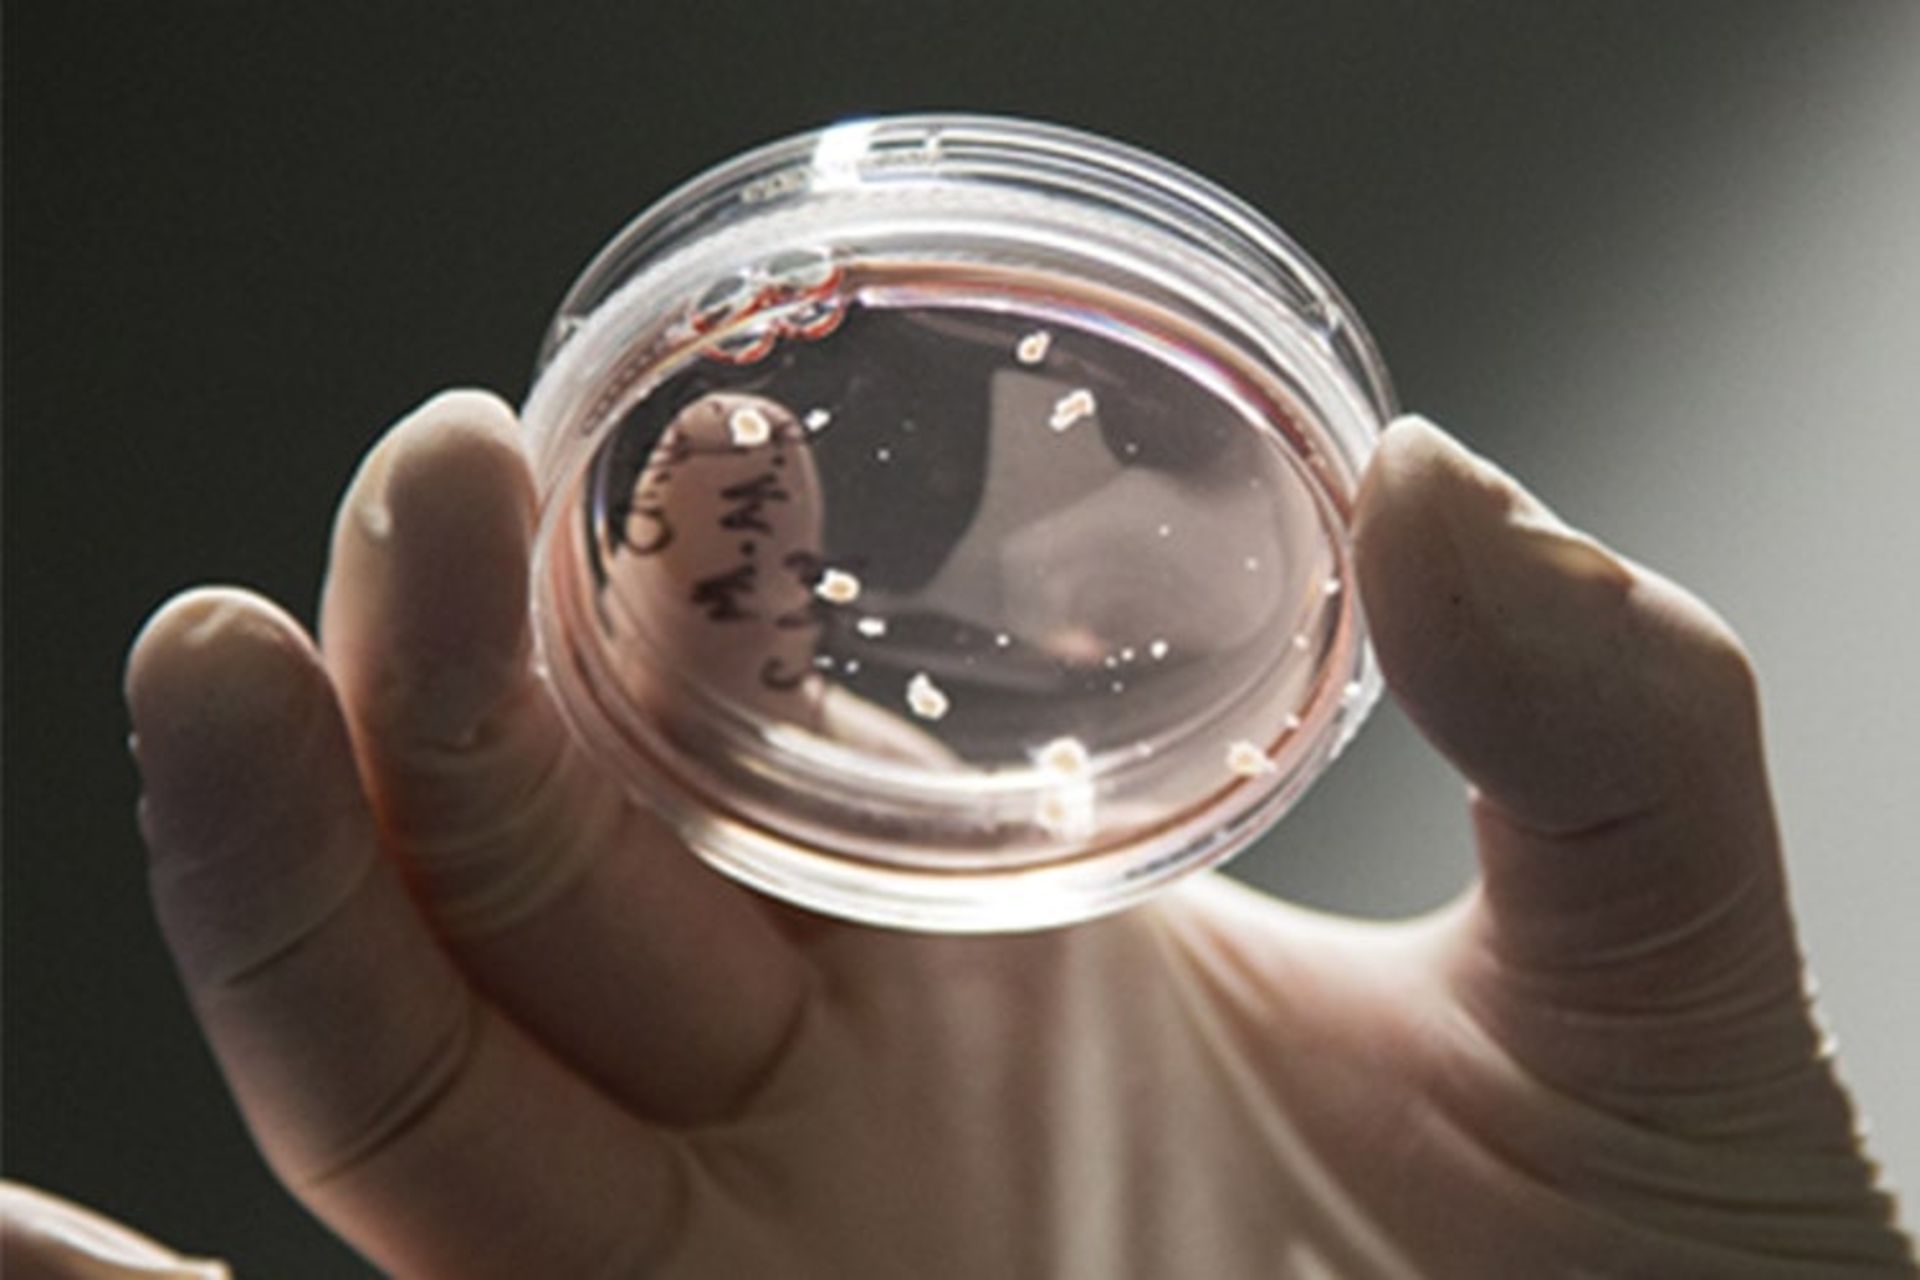

مغزی که در محیط آزمایشگاه بهخودیخود به نخاع متصل شد
پرورش پیچیدهترین ساختار موجود جهان در آزمایشگاه شاید کار ناممکنی بهنظر برسد؛ اما این امر موجب نشده پژوهشگران از تلاش دست بردارند. اکنون و پس از سالها کار، پژوهشگران انگلیسی یکی از مغزهای پیچیدهی مینیاتوری را در ظرفی آزمایشگاهی پرورش دادند که رفتاری غیرعادی دارد. این گلولههای ریز خاکستری از حدود دو میلیون نورون سازمانیافته تشکیل شدهاند و شبیه مغز جنین انسان در ۱۲ تا ۱۳ هفتگی هستند. در این مرحله، این ارگانوئیدهای مغزی به آن اندازه پیچیده نیستند که فکر یا احساس یا آگاهی داشته باشند؛ اما این موجب نمیشود کاملا ساکن باشند.
هنگامیکه این ارگانوئیدها درکنار قطعهای از نخاع و نیز تکهای از بافت عضلانی موش قرار داده شد، این گلولههای بدون کالبد که بهاندازهی یک نخود بودند، با فرستادن ساقههای پیچکمانندی بهسوی همسایگان خود آنها را کاوش کردند. پژوهشگران که برای بررسی این فرایندها از میکروسکوپهایی استفاده کرده بودند که در تمام مدت درحالثبت وقایع بودند، برقراری اتصال خودبهخودی مغزهای مینیاتوری با قطعهی نخاع و بافت ماهیچه را مشاهده کردند. مادلین لنکستر، دانشمند عصبشناس و پژوهشگر این مطالعه، از این ساختارها با عنوان «مغزهای کوچک درحالحرکت» نام میبرد.
حرکت آنها، تنها مهارت آنها نیست. همچنین، این مغزهای ریز نخستین نمونههای ایجاد حرکت عضلانی بودند؛ درست مانند نورونهای حرکتی موجود در مغز ما. پژوهشگران با نظارت بر مغزهای مینیاتوری انقباضهای عضلانی مشاهدهشدنی و کنترلشدهای را شاهد بودند. جالب این است که بهوسیلهی تحریک یکی از رشتههای آکسون، انقباض ماهیچهای سازمانیافته و قدرتمندی اتفاق میافتاد. نویسندگان در مقالهی خود نوشتند:
پس از دوسه هفته کشت همراه، رشتههای متراکم آکسون بین ارگانوئید و نخاع تشکیل شد و سیناپسهای بین آکسونها و نورونهای خارجشده از نخاع مشاهدهشدنی بودند. تصویربرداری زنده از بافت عضلانی موش نشاندهندهی انقباضهای پراکنده و نامنظم در این بافت بود.
ارگانوئیدهای مغزی یکی از ابزارهای برتر برای درک توسعهی مغز انسان و بیماریها هستند؛ ولی کشت آنها فراتر از مرحلهی خاص مشکلسازی است. امروزه، بیشتر ارگانوئیدهای مغزی از سلولهای بنیادی انسانی پروش مییابند که بهطور خودبهخود در ساختارها و لایههای موردنیاز برای توسعهی مغزی اولیه سازماندهی مییابند. مشکل اینجا است که وقتی این مجموعه به اندازهای خاص رسید، بخش میانی ازلحاظ موادغذایی و اکسیژن محروم میماند و دیگر کارایی ندارد. پژوهش حاضر یکی از نخستین پژوهشها درزمینهی غلبه بر این محدودیت است. با برش ارگانوئیدها و قراردادن آنها روی غشایی خالخالی مغزهای مینیاتوری میتوانستند از هوای بالا و موادمغذی قرار گرفته در بخش پایین محیط کشت استفاده کنند و پس از یک سال، همچنان در ظرفهای آزمایشگاهی سالم باقی بمانند. بااینحال، هرچند تصور میشود این مغزهای مینیاتوری پیچیدهتر از قبل هستند، هنور بسیار کوچک است و ازنظر پیچیدگی از همتایان طبیعی خود بسیار فاصله دارند. باوجوداین، نویسندگان امیدوارند موفقیت رویکرد جدید آنها به پژوهشگران دیگر اجازه دهد که بتوانند بیماریهای مغز را با جزئیات بیشتر از قبل مدلسازی کنند. نویسندگان نوشتهاند:
این نتایج میتواند به مطالعهی بیماریهای توسعهی عصبی جسم پینهای و ناتوازنی مدارهای عصبی در بیماری صرع و دیگر نقایصی کمک کند که بهنظر میرسد در آنها مشکلاتی در ارتباطات عصبی مغز وجود داشته باشد (نظیر اوتیسم و اسکیزوفرونی).